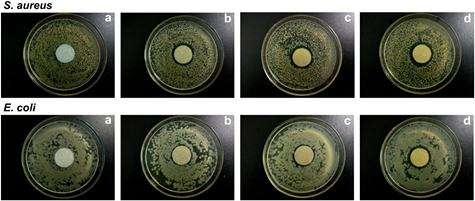
Figure 12.

Abstract
An eco-friendly approach for the preparation of silver nanoparticles (AgNPs) from silver nitrate solution using aqueous Eriobotrya japonica leaf extract was investigated. The reduction of silver ions in solution was monitored using UV–visible absorption spectroscopy, and the surface plasmon resonance of AgNPs at 435 nm was observed. The proper condition to biosynthesize AgNPs using E. japonica leaf extract was optimized by UV–visible absorption spectroscopy and dynamic light scattering measurement (DLS). The biosynthesised nanoparticles were characterised using transmission electron microscopy (TEM), scanning electron microscopy (SEM), energy dispersive x-ray spectroscopy (EDX), DLS, x-ray diffraction (XRD) and Fourier transform infrared spectroscopy (FTIR). XRD and EDX analyses confirmed the crystalline character of AgNPs and the presence of elemental silver. The prepared AgNPs were spherical in shape, and their average particle size determined by TEM was about 20 nm. Furthermore the AgNPs were found to exhibit effective antibacterial activities against Escherichia coli and Staphylococcus aureus.
Export citation and abstract BibTeX RIS

Original content from this work may be used under the terms of the Creative Commons Attribution 3.0 licence. Any further distribution of this work must maintain attribution to the author(s) and the title of the work, journal citation and DOI.
1. Introduction
In the past ten years, silver nanoparticles (AgNPs) have been one of the extensively studied nanomaterials. They have attracted a great deal of attention due to their unique physical, chemical, optical and biological properties, and found tremendous applications in biomedicine, drug delivery, topical ointments and creams, electronics, optics, catalysis, food industry, agriculture, textile industry and water treatment [1, 2]. Various chemical and physical approaches have been developed to prepare AgNPs. Among them, the chemical reduction is most widely used. These approaches are inevitably associated with the use of hazardous chemicals such as reductants, stabilizers and organic solvents, or have special requirements for the employed techniques such as high energy radiation, microwave irradiation and inert gas condensation [3–7]. Therefore, there is an increasing need to develop the eco-friendly, non-toxic and cost-effective approaches for the preparation of AgNPs without the application of toxic chemicals and special equipments. In recent years, the biological approaches using microorganisms and plant extracts have become valuable alternatives to chemical synthesis.
Many researches have been reported on the biosynthesis of AgNPs using naturally occurring reductants such as bacteria, fungus and plant extracts [1, 2, 7–9]. The production of AgNPs using the extract of microorganisms (e.g. phytopathogen Xanthomonas oryzae, microalga scenedesmus, Chlorella vulgaris, Penicillium species, etc.) usually deals with the isolation and incubation of bacterial strains as well as the reduction of silver ions, and therefore its process is complex and time-consuming [10–13]. Furthermore, the rate of synthesis is slow, although the synthesis conditions are mild [7]. For example, when the culture supernatant of Chlorella vulgaris cells was used for biosynthesis reaction at 50 °C, it took about 24 h to change silver nitrate solution to dark brown and obtain enough AgNPs [12].
In comparison to microorganisms, the application of plant extracts for the synthesis of AgNPs is more advantageous in terms of resource availability, security, reaction rate and convenience, and feasibility of large scale synthesis [7, 14]. It has been proved that many plant extracts are suitable for the phytosynthesis of AgNPs [1, 2, 7–9, 14–21]. Several factors including pH, dosage of plant extract, dosage of silver ions, reaction temperature and time affect the phytosynthesis of AgNPs [7, 9, 14, 17–20]. The reduction rate of silver ions is associated with the species of plants and the key active components of plant extracts [17]. It was reported that among pine, persimmon, ginkgo, magnolia and platanus leaf extracts, magnolia leaf broth was the best reducing agent in terms of synthesis rate and conversion to AgNPs [17]. In the process of the synthesis of AgNPs, some active components of plant extracts not only act as reducing agents, but also play an important role in the capping and stabilizing of nanoparticles [14, 17]. The polysaccharides present in carambola fruit extract are a very typical case, and they are responsible for the formation and stability of AgNPs [14]. The AgNPs synthesized by plant extracts can exhibit good antibacterial activities against a variety of bacteria [14, 19, 21].
Eriobotrya japonica (loquat) is native to southeastern China but has been cultivated worldwide in almost all warm and subtropical regions. It is a large evergreen shrub or small tree, grown commercially for its fruit, and also cultivated as an ornamental plant. The fruits, leaves and seeds of E. japonica have great nutritional value and medicinal properties due to the presence of polyphenols, flavonoids glycosides, amygdalins, vitamin, carotene, pectin, enzymes, organic acids etc. The extracts from them can exhibit antioxidant [22–24], anti-inflammatory and antinociceptive [25, 26], antiviral [27], and even anticancer actions [28]. The dried leaf of E. japonica is used as a famous traditional Chinese medicine for treatment to clear away lung-heat, eliminate phlegm, lower the adverse-rising energy, relief cough and regulate the stomach to restrain vomiting. For instance, the leaves of E. japonica combined with other ingredients have long been utilized to prepare the well-known loquat paste (pipa gao), a commercially sold medicinal product acting as an effective demulcent and an expectorant [29]. In terms of the comprehensive utilization of E. japonica leaves as well as the recent developments of plant-mediated AgNPs synthesis, it is significant to carry out the research on the biosynthesis of AgNPs using the extracts of E. japonica leaves. The aqueous E. japonica leaf extract is rich in nutritional and bioactive components such as triterpenic acids, flavonoids, polysaccharides and proteins, etc [30, 31], which could be used as reductants and stabilizers for the synthesis and stabilization of AgNPs from silver nitrate solution. In this study, a green approach for the synthesis of AgNPs using aqueous E. japonica leaf extract was described. The AgNPs thus obtained was characterised by transmission electron microscopy (TEM), scanning electron microscopy (SEM) with energy dispersive x-ray spectroscopy (EDX), dynamic light scattering (DLS) analysis, x-ray diffraction (XRD) analysis and Fourier transform infrared (FTIR) spectroscopy. Additionally, the antibacterial activities of AgNPs against Escherichia coli and Staphylococcus aureus were examined.
2. Experimental
2.1. Materials
Silver nitrate was purchased from Sinopharm Chemical Reagent Co. Ltd., China. Eriobotrya japonica leaf was collected from the orchard in the suburb of Suzhou, China. Suzhou is one of the important and famous localities of E. japonica in China.
2.2. Preparation of E. japonica leaf extract
E. japonica leaf was thoroughly washed with tap water, dried in the oven at 60 °C, and then grounded into powder for storage. To prepare the aqueous E. japonica leaf extract, 5 g of the leaf powder was mixed with 150 ml of deionized water in the 250 ml Erlenmeyer flask. The mixture was then heated in the oscillator at 80 °C for 90 min. Afterwards, the extract aqueous solution was centrifuged at 4000 rpm for 20 min to remove impurities. Subsequently, the supernatant was collected, and finally stored at −4 °C for further experiments.
2.3. Synthesis of AgNPs
For the typical reduction of silver ions to AgNPs, 2 ml of the freshly prepared extract was added to 48 ml of the aqueous silver nitrate solution (1 mM) and then the mixture was incubated in the oscillator at 80 °C under moderate stirring for a period of time. As the reaction proceeded, the color change from colorless to yellowish brown was observed and recognized for the formation of AgNPs. The effect of reaction time was studied by incubating the reaction mixture (2 ml E. japonica leaf extract, 1 mM AgNO3, 80 °C) for different time intervals (5, 10, 20, 30, 60 and 80 min). To evaluate the effect of reaction temperature on the biosynthesis of AgNPs, the reaction mixtures containing 2 ml extract and 1 mM AgNO3 were incubated at different temperatures (25, 40, 60 and 80 °C) for 60 min. The effect of initial silver ions on the green synthesis of AgNPs was investigated by varying the silver nitrate concentration from 0.5 to 2.0 mM.
2.4. Characterisation of AgNPs
The bio-reduction process of silver ions in solution was monitored using UV–visible absorption spectroscopy. At regular time intervals, the reaction mixture was sampled and diluted. The UV–visible absorption spectra were recorded on the UV-1800 UV–visible absorption spectrophotometer (Shimadzu Co., Japan) from 200 to 800 nm at a resolution of 1 nm.
The particle size distribution and zeta potential of the prepared AgNPs colloid were determined by the DLS technique using Zetasizer Nano ZS 90 (Malvern Instruments Ltd., UK) within the range of 0.1–10 000 nm at a scattering angle of 90° and 25 °C. For the hydrodynamic diameter measurement, 1 ml of the sample was transferred into a disposable plastic cuvette, and automatically equilibrated in the instrument for 2 min. The data were recorded in triplicate. For the zeta potential analysis, 1 ml of the sample was injected into the zeta cell, and the measurements were repeated three times after equilibration.
To determine the size and morphology of the biosynthesised AgNPs, one drop of the reaction mixture was deposited on a silicon wafer, and then the sample was left to evaporate and dry completely. The SEM measurement at a 3 kV accelerated voltage as well as the EDX analysis was conducted on the S-4800 scanning electron microscope (Hitachi High Technologies America Inc., Japan) equipped with energy dispersive spectrometer.
The TEM analysis was also performed to determine the morphology and size of AgNPs on the HT7700 transmission electron microscope (Hitachi High Technologies America Inc., Japan) operated at an accelerating voltage of 100 kV. For this purpose, one drop of the reaction mixture loaded on the copper grid was allowed to evaporate completely under infrared light before investigation.
The XRD analysis of the biosynthesised AgNPs colloid deposited on a glass slide to form a thin film was performed on the X'Pert-Pro MPD x-ray diffractometer (PANalytical B.V., NL) equipped using the Cu-Kα radiation of wavelength 0.154 18 nm. The scattering angle range was 30°–80°.
The FTTR spectrum of the synthesised AgNPs was recorded by a KBr pellet method on the Nicolet 5700 FTIR spectrometer (Thermo Fisher Scientific Inc., USA) at a resolution of 2 cm−1. For the purification of the synthesised AgNPs, the mixture after reaction was subjected to centrifugation at 10 000 rpm for 10 min and then the obtained precipitation was washed with deionized water. This procedure was repeated three times to eliminate the uncoordinated bio-molecules on the surface of AgNPs. The final product was collected and dried in the vacuum oven.
2.5. Antibacterial activity evaluation of AgNPs
The antibacterial activity of the biosynthesised AgNPs was determined using the disc diffusion method. Two different bacterial strains E. coli and S. aureus were inoculated into the nutrient broth and kept in the rotatory shaker for incubation at 37 °C for 24 h. 100 µl of the overnight incubated bacterial cultures after a series of dilution were uniformly spread on the surface of the freshly prepared agar medium with the help of a sterilized triangle glass rod. Subsequently, the sterilized circular filter papers with a diameter of 25 mm which were impregnated with the prepared AgNPs of different concentrations were gently put down on the surface of inoculated nutrient agar plates by means of a sterilized tweezer. Eventually, the zone of inhibition in millimeter was measured after incubation at 37 °C for 24 h.
3. Results and discussion
3.1. UV–visible absorption spectroscopy
It is well known that AgNPs exhibit strong absorption band and generate specific color in solution due to the surface plasmon resonance (SPR). The formation of AgNPs was monitored by color change observation and UV–vis absorption spectroscopy. Figures 1 and 2 display the color change and UV–visible spectra of the mixture before and after reaction, respectively. The reduction of silver ions into AgNPs during exposure to E. japonica leaf extract was evidenced by the change of color from colorless to yellowish brown and a characteristic, well-defined SPR band at around 435 nm, both of which are attributed to the excitation of the SPR of AgNPs [32, 33].
Figure 1. Color change of silver nitrate solution before (left) and after (right) the synthesis of AgNPs for 60 min.
Download figure:
Standard image High-resolution imageFigure 2. UV–visible absorption spectra of the biosynthesised AgNPs at different reaction times.
Download figure:
Standard image High-resolution image3.2. Conditions of the AgNPs synthesis
3.2.1. Reaction time.
The effect of reaction time on the biosynthesis of AgNPs was studied by using UV–visible absorption spectroscopy. Figure 2 shows the UV–visible absorption spectra of the mixture of E. japonica leaf extract and silver nitrate as a function of time. It can be seen that AgNPs began to generate within 5 min after the addition of silver nitrate to the E. japonica leaf extract solution. As the reaction time was prolonged, the intensity of the SPR peak at 435 nm increased gradually, indicating an increasing number of AgNPs formed in the mixture. The UV–visible absorption spectrum recorded after 60 min showed no obvious increase in absorbance (inserted figure), indicating the AgNPs synthesis reaction tended towards equilibrium. Thus, the optimum time for the completion of reaction in our study was 60 min. The rapid generation of AgNPs is attributed to the great reducibility of the chemical components in the E. japonica leaf extract, which also play a significant role in stabilizing nanoparticles formed in the medium.
3.2.2. Temperature.
The reaction temperature has great impact on the transformation of silver ions to AgNPs. The effect of temperature on the biosynthesis of AgNPs was studied by performing reactions at different temperatures (25, 40, 60 and 80 °C). The UV–visible absorption spectra of the synthesised AgNPs at different temperatures are illustrated in figure 3(a). At a relatively low temperature, the intensity of SPR peak was a little weak and the width of the SPR band was broad, implying that few nanoparticles was formed in number and a distribution in particle size was wide. However, as the reaction temperature was elevated from 25 to 80 °C, the significant increase in the intensity of the SPR peak was observed due to the enhanced formation rate of AgNPs. In addition, there was a blue shift in the SPR peak location from 451 nm to 435 nm (inserted figure), a decrease in particle size from 76.10 nm to 54.47 nm, and a decline in polydispersity index from 0.571 to 0.281 (figure 3(b)). These results reveal that higher temperature is in favor of the formation of AgNPs with higher yields, smaller sizes and uniform size distribution, which is in accordance with previous reports [17, 18]. In sum, the temperature chosen in our study to fabricate AgNPs was 80 °C.
Figure 3. UV–visible absorption spectra of the biosynthesised AgNPs at different temperatures (a), and the particle size and polydispersity index determined by DLS as a function of reaction temperature (b).
Download figure:
Standard image High-resolution image3.2.3. Silver nitrate concentration.
The effect of silver nitrate precursor concentration (0.5, 1.0, 2.0 and 4.0 mM) on the formation of AgNPs was evaluated by UV–visible absorption spectroscopy (figure 4(a)). Clearly, the SPR peak of AgNPs became more distinct with increasing initial silver nitrate concentration, indicating that more AgNPs were synthesised as a consequence of abundant silver ions in the medium. Moreover, each of the four SPR bands had a relatively narrow peak with a good symmetry, signifying a narrow and uniform size distribution of the synthesised AgNPs with spherical shape, which was then demonstrated by the relatively low polydispersity indexes (figure 4(b)). However, the Z-average particle size of AgNPs measured by DLS had a slight tendency to become larger with an increase in silver nitrate concentration. Therefore, taking into account of both the particle size and polydispersity index of AgNPs, the final silver nitrate concentration employed in our study was 1 mM.
Figure 4. UV–visible absorption spectra of the biosynthesised AgNPs at different silver nitrate concentrations (a), and the particle size and polydispersity index determined by DLS as a function of silver nitrate concentration (b).
Download figure:
Standard image High-resolution image3.3. Charaterisation of the biosynthesised AgNPs
The SEM, EDX, TEM and DLS techniques were applied to determine the size, shape and morphologies of AgNPs in order to give further insights into the detailed features of biosynthesised AgNPs.
The representative SEM images at two different magnifications (×50 000 and ×70 000) are shown in figure 5, and the related EDX spectrum is given in figure 6. The AgNPs obtained were mostly spherical in shape with a narrow size distribution in the range from 46 to 70 nm. Several large particles viewed probably resulted from the agglomeration of small ones. The EDX profile showed strong signals for silver atoms. The strong signal peak at 3 keV in the EDX spectrum was typical of the absorption of silver nanocrystallites [19], demonstrating the presence of AgNPs. Interestingly, some adjoint elements such as C, O and Au were also detected. C and O are very likely associated with the organic compounds from the extract adsorbed on the surface of AgNPs, which play a crucial role in the reduction and stability of AgNPs [19]. The appearance of Au in the spectrum comes from the sputtered gold layer.
Figure 5. SEM micrographs of the biosynthesised AgNPs using E. japonica leaf extract magnified 50 000 (a), and 70 000 (b).
Download figure:
Standard image High-resolution imageFigure 6. EDX spectrum of the biosynthesised AgNPs using E. japonica leaf extract.
Download figure:
Standard image High-resolution imageThe morphology and size dimension of the biosynthesised AgNPs were intuitively obtained from the TEM image (figure 7), and the size distribution was also given by the DLS analysis (figure 8). The AgNPs were spherical in shape with different size distributions. It should be noted that the mean particle size (around 19.75 nm) determined by the TEM analysis was significantly smaller than that (about 54.47 nm) measured by the DLS method. This discrepancy could be possibly due to the adsorption of organic stabilizers from the extract on the surface of AgNPs, the aggregation of some small particles and the adsorption of water on the stabilized AgNPs [34, 35], all of which could have a negative effect on the average particle size obtained by the DLS method. The zeta potential value of E. japonica leaf extract meditated AgNPs was −20.4 mV (figure 9), proving the interaction of AgNPs with the biomolecules from E. japonica leaf extract. Thus, there exist repulsive forces between negatively charged AgNPs, which are responsible for the moderate stability of nanoparticles in the suspension.
Figure 7. TEM image of the biosynthesised AgNPs using E. japonica leaf extract (a), and the histogram of AgNPs size distribution (b).
Download figure:
Standard image High-resolution imageFigure 8. Particle size distribution of the biosynthesised AgNPs at 25 °C (a) and 80 °C (b).
Download figure:
Standard image High-resolution imageFigure 9. Zeta potential of the AgNPs biosynthesised at the optimum condition.
Download figure:
Standard image High-resolution imageThe crystalline nature of the biosynthesised AgNPs was confirmed by XRD pattern displayed in figure 10. The diffraction peaks at the 2θ values of 38.11°, 44.33°, 64.35° and 77.62° corresponded to the 111, 200, 220 and 311 crystallographic planes, respectively. This suggests that the prepared AgNPs are faced centred cubic in nature. In addition, the unsigned peaks may be associated with the organic compounds which originate from the E. japonica leaf extract and function as reductants and stabilizers for AgNPs in the mixture [20].
Figure 10. XRD pattern of the biosynthesised AgNPs using E. japonica leaf extract.
Download figure:
Standard image High-resolution imageThe FTIR spectroscopy was carried out to investigate the surface chemistry composition of AgNPs capped by the biomolecules in E. japonica leaf extract. Figure 11 shows the FTIR spectra of biosynthesised AgNPs and E. japonica leaf extract. The band at 3419.8 cm−1 is assigned to the O–H and N–H stretching vibration of carboxylic acid and proteins from the extract. The peak at 1640.7 cm−1 corresponds to the bending vibration of amide I and arises due to the carbonyl stretching vibration in the amide linkage of proteins [21, 36]. Such observations suggest the presence and binding of proteins with AgNPs which may be involved in the process of their formation and stabilization. Earlier phytochemical studies with E. japonica leaf have revealed the presence of various triterpenic acids [31], flavonoids [30], sesquiterpenes glycosides [37], polysaccharides and proteins etc in the E. japonica leaf. These constituents can be used as the reductants for the AgNPs from silver nitrate under proper conditions and further can stabilize the generated AgNPs in the medium.
Figure 11. FTIR spectra of the biosynthesised AgNPs and E. japonica leaf extract.
Download figure:
Standard image High-resolution image3.4. Antibacterial activities of the biosynthesised AgNPs
The antibacterial activities of the biofabricated AgNPs by E. japonica leaf against two bacterial strains-E. coli and S. aureus were studied by measuring the diameter of the inhibition zone. Figures 12 and 13 show the inhibition zone of the biosynthesised AgNPs against the two bacterial strains. It is clear from the obtained results that as the concentration of the biosynthesised AgNPs increased, the zone of inhibition increased gradually. And besides, the biosynthesised AgNPs exhibited more excellent antibacterial property against S. aureus than E. coli; the similar result was also found for the biosynthesised AgNPs using latex of Syandenium grantii Hook f [21]. The potent antibacterial properties of AgNPs may be attributed to the released silver ions, which could have an interaction with microorganisms by means of their attaching to the surface of the cell membranes of bacteria, penetrating into the bacterial cells, and affecting the membrane permeability and respiration. In the bacterial cells, AgNPs could even interact with sulfur- and phosphorus-containing compounds like DNA to give rise to the deadly impairment of microorganisms [38, 39].
Figure 12. Inhibition zone of the biosynthesised AgNPs against S. aureus and E. coli: AgNPs concentration: (a) 0 mg l−1, (b) 25 mg l−1, (c) 50 mg l−1, and (d) 100 mg l−1.
Download figure:
Standard image High-resolution imageFigure 13. Antibacterial activities of the biosynthesised AgNPs against S. aureus and E. coli.
Download figure:
Standard image High-resolution image4. Conclusions
An eco-friendly and cost-effective protocol for the synthesis of AgNPs by utilizing a renewable natural resource E. japonica leaf was proposed. The proper condition to biosynthesise AgNPs using E. japonica leaf extract was optimized. It was found that the AgNPs synthesis reaction tended towards completion with 60 min and higher temperature was beneficial for the formation of smaller particles. In addition, the initial silver nitrate concentration also had great impact on the size distribution of AgNPs. The biosynthesised AgNPs were characterised by UV–visible absorption spectroscopy, SEM, EDX, TEM, DLS, XRD and FITR. The AgNPs were spherical in shape, and their average particle sizes determined by TEM and DLS were 19.75 nm and 54.47 nm, respectively. The biogenic AgNPs exhibited good antibacterial activities against E. coli and S. aureus. Further research on the AgNPs biosynthesised using E. japonica leaf extract could bring a promising application in the fields of medicine and hygiene.
Acknowledgments
This study was funded by Jiangsu Provincial Natural Science Foundation of China (BK20131178), Jiangsu Provincial Key Research and Development Program of China (BE2015066), and the Priority Academic Program Development (PAPD) of Jiangsu Higher Education Institutions (No. 2014-37).